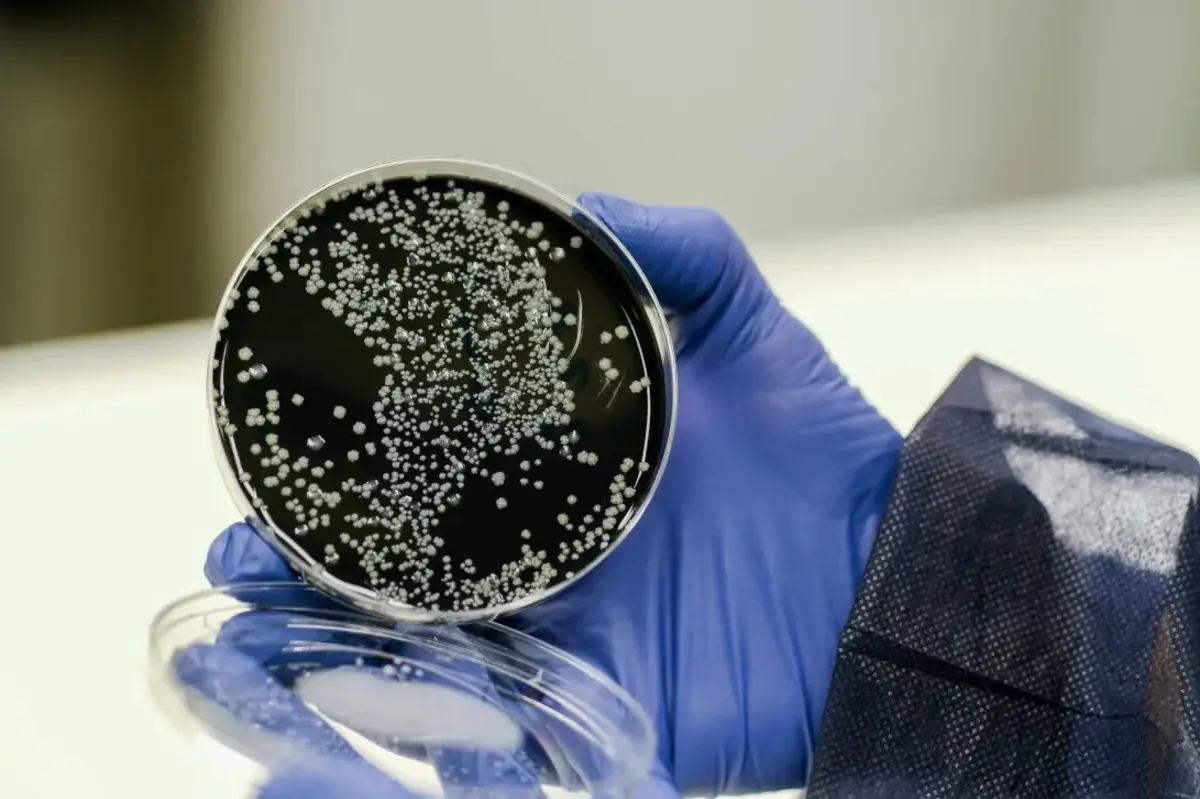
Imagem de contexto do artigo Detetada legionela nos balneários de escola secundária em Lisboa

Arquivo Global Imagens
A bactéria legionela foi detetada em balneários da Escola Secundária Padre António Vieira, em Lisboa, disse hoje à Lusa fonte do Ministério da Educação, adiantando que o risco é "baixo a moderado", pelo que o espaço não foi interditado.
Em resposta a questões da Lusa, na sequência de uma denúncia relativa à presença da bactéria no Agrupamento de Escolas de Alvalade, ao qual pertence aquela secundária, o Ministério da Educação confirmou que, no âmbito do plano de manutenção e conservação preventiva da Escola Secundária Padre António Viera, "foram recolhidas amostras, tendo sido registada a presença da bactéria legionela, com risco baixo a moderado, num chuveiro do balneário feminino e num chuveiro do balneário masculino".
"De acordo com os procedimentos da Construção Pública, E.P.E. [antiga Parque Escolar], foi realizado um choque térmico, um choque químico, limpeza e desinfeção e recolha de novas amostras para contra-análise", acrescenta o gabinete do ministro da Educação, João Costa.
Segundo a mesma fonte, dado o "risco baixo a moderado envolvido, e de acordo com a legislação em vigor, os valores apresentados não implicam a interdição do espaço".
"A Construção Pública, E.P.E. continua a acompanhar este caso, estando atualmente a aguardar o resultado das contra-análises", lê-se na resposta à Lusa.
A agência Lusa contactou a direção do Agrupamento de Escolas de Alvalade, mas não obteve resposta até ao momento.
A doença do legionário, provocada pela bactéria "Legionella pneumophila", contrai-se por inalação de gotículas de vapor de água contaminada (aerossóis) de dimensões tão pequenas que transportam a bactéria para os pulmões, depositando-a nos alvéolos pulmonares.
